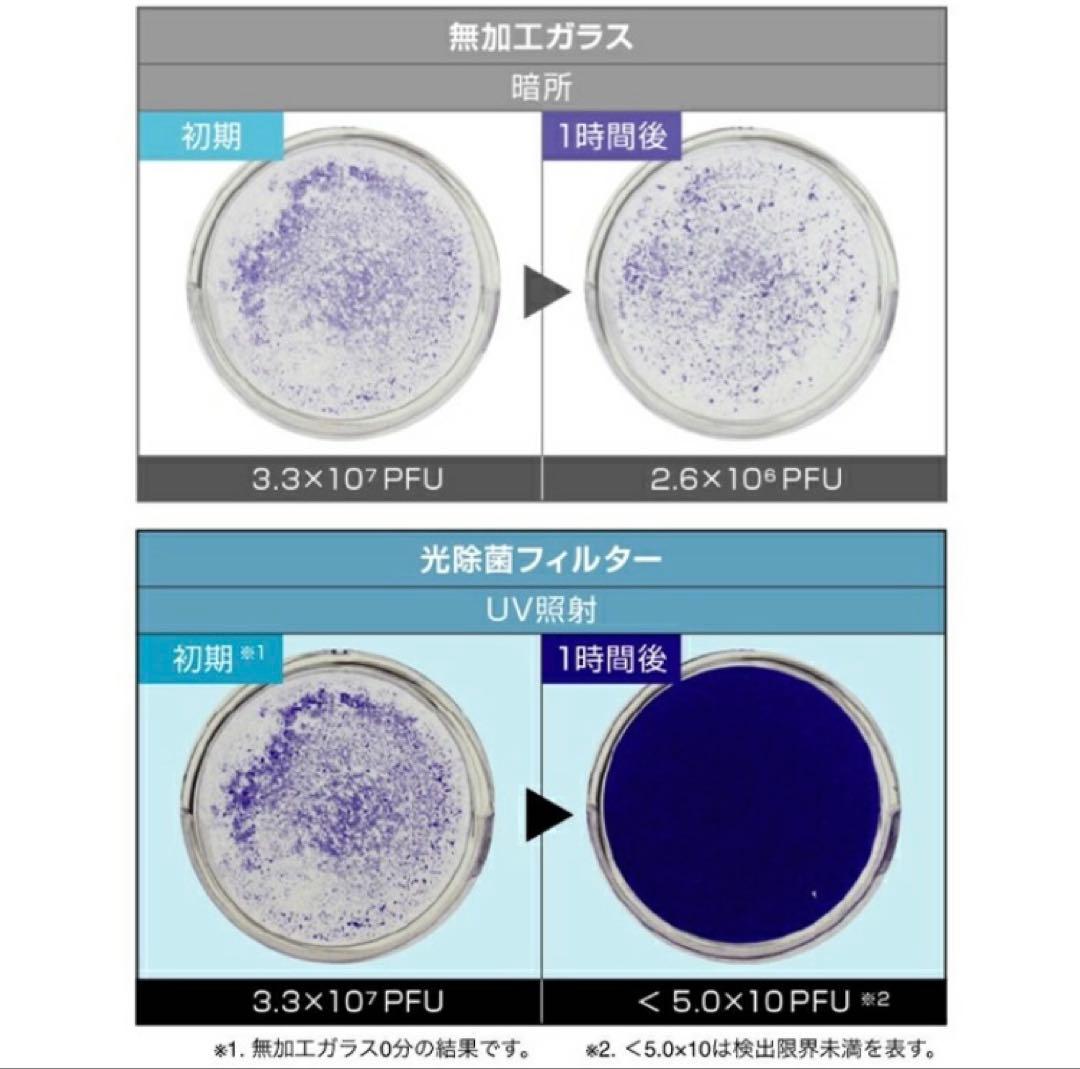
【新品・未使用品】空気清浄機FUJICO Blue Deo MC-S201

マイストア
変更
お店で受け取る
(送料無料)
配送する
納期目安:
2026.04.03 0:24頃のお届け予定です。
決済方法が、クレジット、代金引換の場合に限ります。その他の決済方法の場合はこちらをご確認ください。
※土・日・祝日の注文の場合や在庫状況によって、商品のお届けにお時間をいただく場合がございます。
【新品・未使用品】空気清浄機FUJICO Blue Deo MC-S201の詳細情報
【製品概要】FUJICOのBlue Deo MC-S201は、光触媒技術を利用した空気清浄機です。SHARP 加湿空気清浄機 KC-R50-W 2023年製。新型モデルで、2023年に登場しました。^プラズマクラスター 空気清浄機。コンパクトなデザインで、家庭やオフィスに最適です。♪送料込!2020年製ダイキン 加湿空気清浄機 MCK55XY-T。【性能と機能】運転モードは弱、標準、強の3つがあり、風量は最大で0.70m/minを実現。美品 DAIKIN ダイキン 加湿ストリーマ空気清浄機 MCK70TKS-T。消費電力は、運転モードに応じて6.4Wから12.5Wまで変化します。極美品✨dyson PH03 Purifier Humidify + Cool。運転音も静かで、弱モードでは21dBと非常に静かです。【新品未開封】シャープ 加湿空気清浄機 18畳 SHARP KC-G40-W。【サイズと重量】本体のサイズは幅187mm、奥行145mm、高さ268mmで、重量は1.3kgと軽量です。ダイキン 加湿空気清浄機 2020年製 ~31畳 北九州市福岡市限定。家庭用交流100Vで動作し、設置も簡単です。DAIKIN 空気清浄機 MCK 70YN-T 2022年製。【定価】29,480円(税込)【製品情報】- ブランド: FUJICO- モデル名: MC-S201- 製品名: Blue Deo- 色: ホワイト- サイズ: 幅187mm×奥行145mm×高さ268mm- 重量: 1.3kg- 電源: 家庭用交流100V(50/60Hz)- 運転モード: 弱、標準、強- 風量(m/min): 弱:0.10, 標準:0.24, 強:0.70- 消費電力(W): 弱:6.4, 標準:9.6, 強:12.5- 運転音(dB): 弱:21, 標準:26, 強:46- 製造国: 日本ご覧いただきありがとうございます。【ほぼ未使用】Panasonic 空間除菌脱臭機 ジアイーノ F-MV4100。
ベストセラーランキングです
近くの売り場の商品
カスタマーレビュー
オススメ度 4.6点
現在、3936件のレビューが投稿されています。